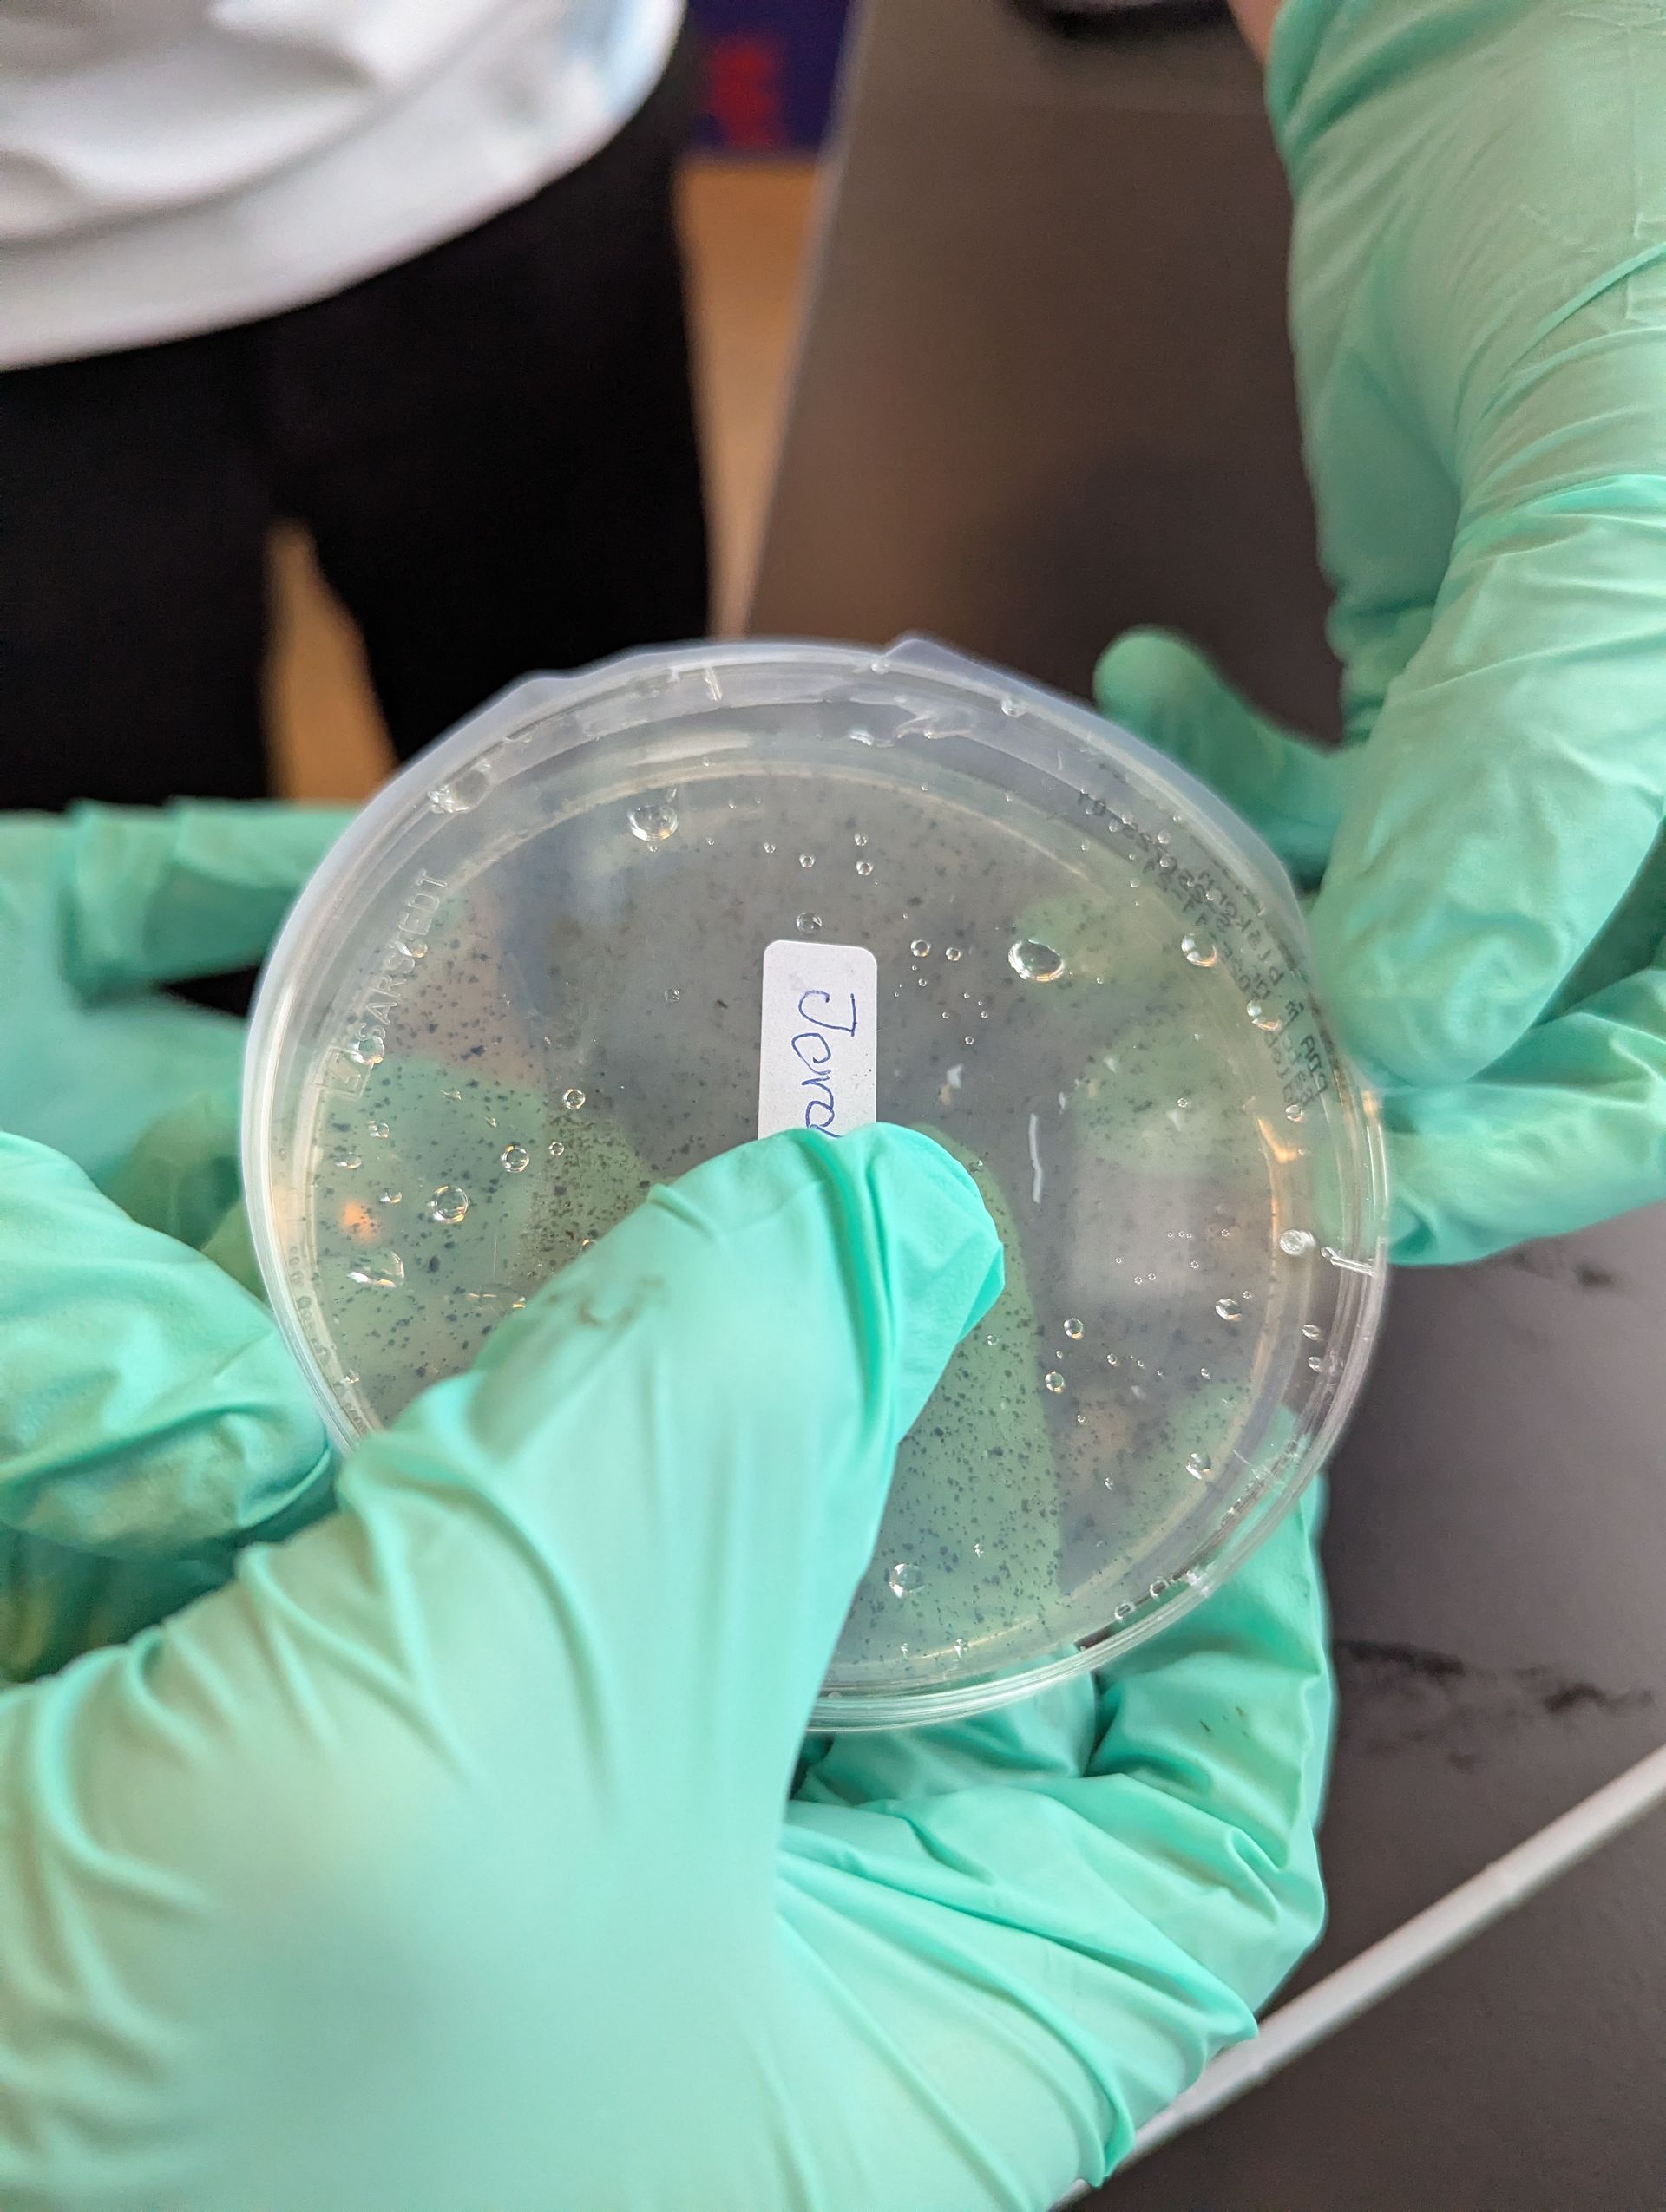
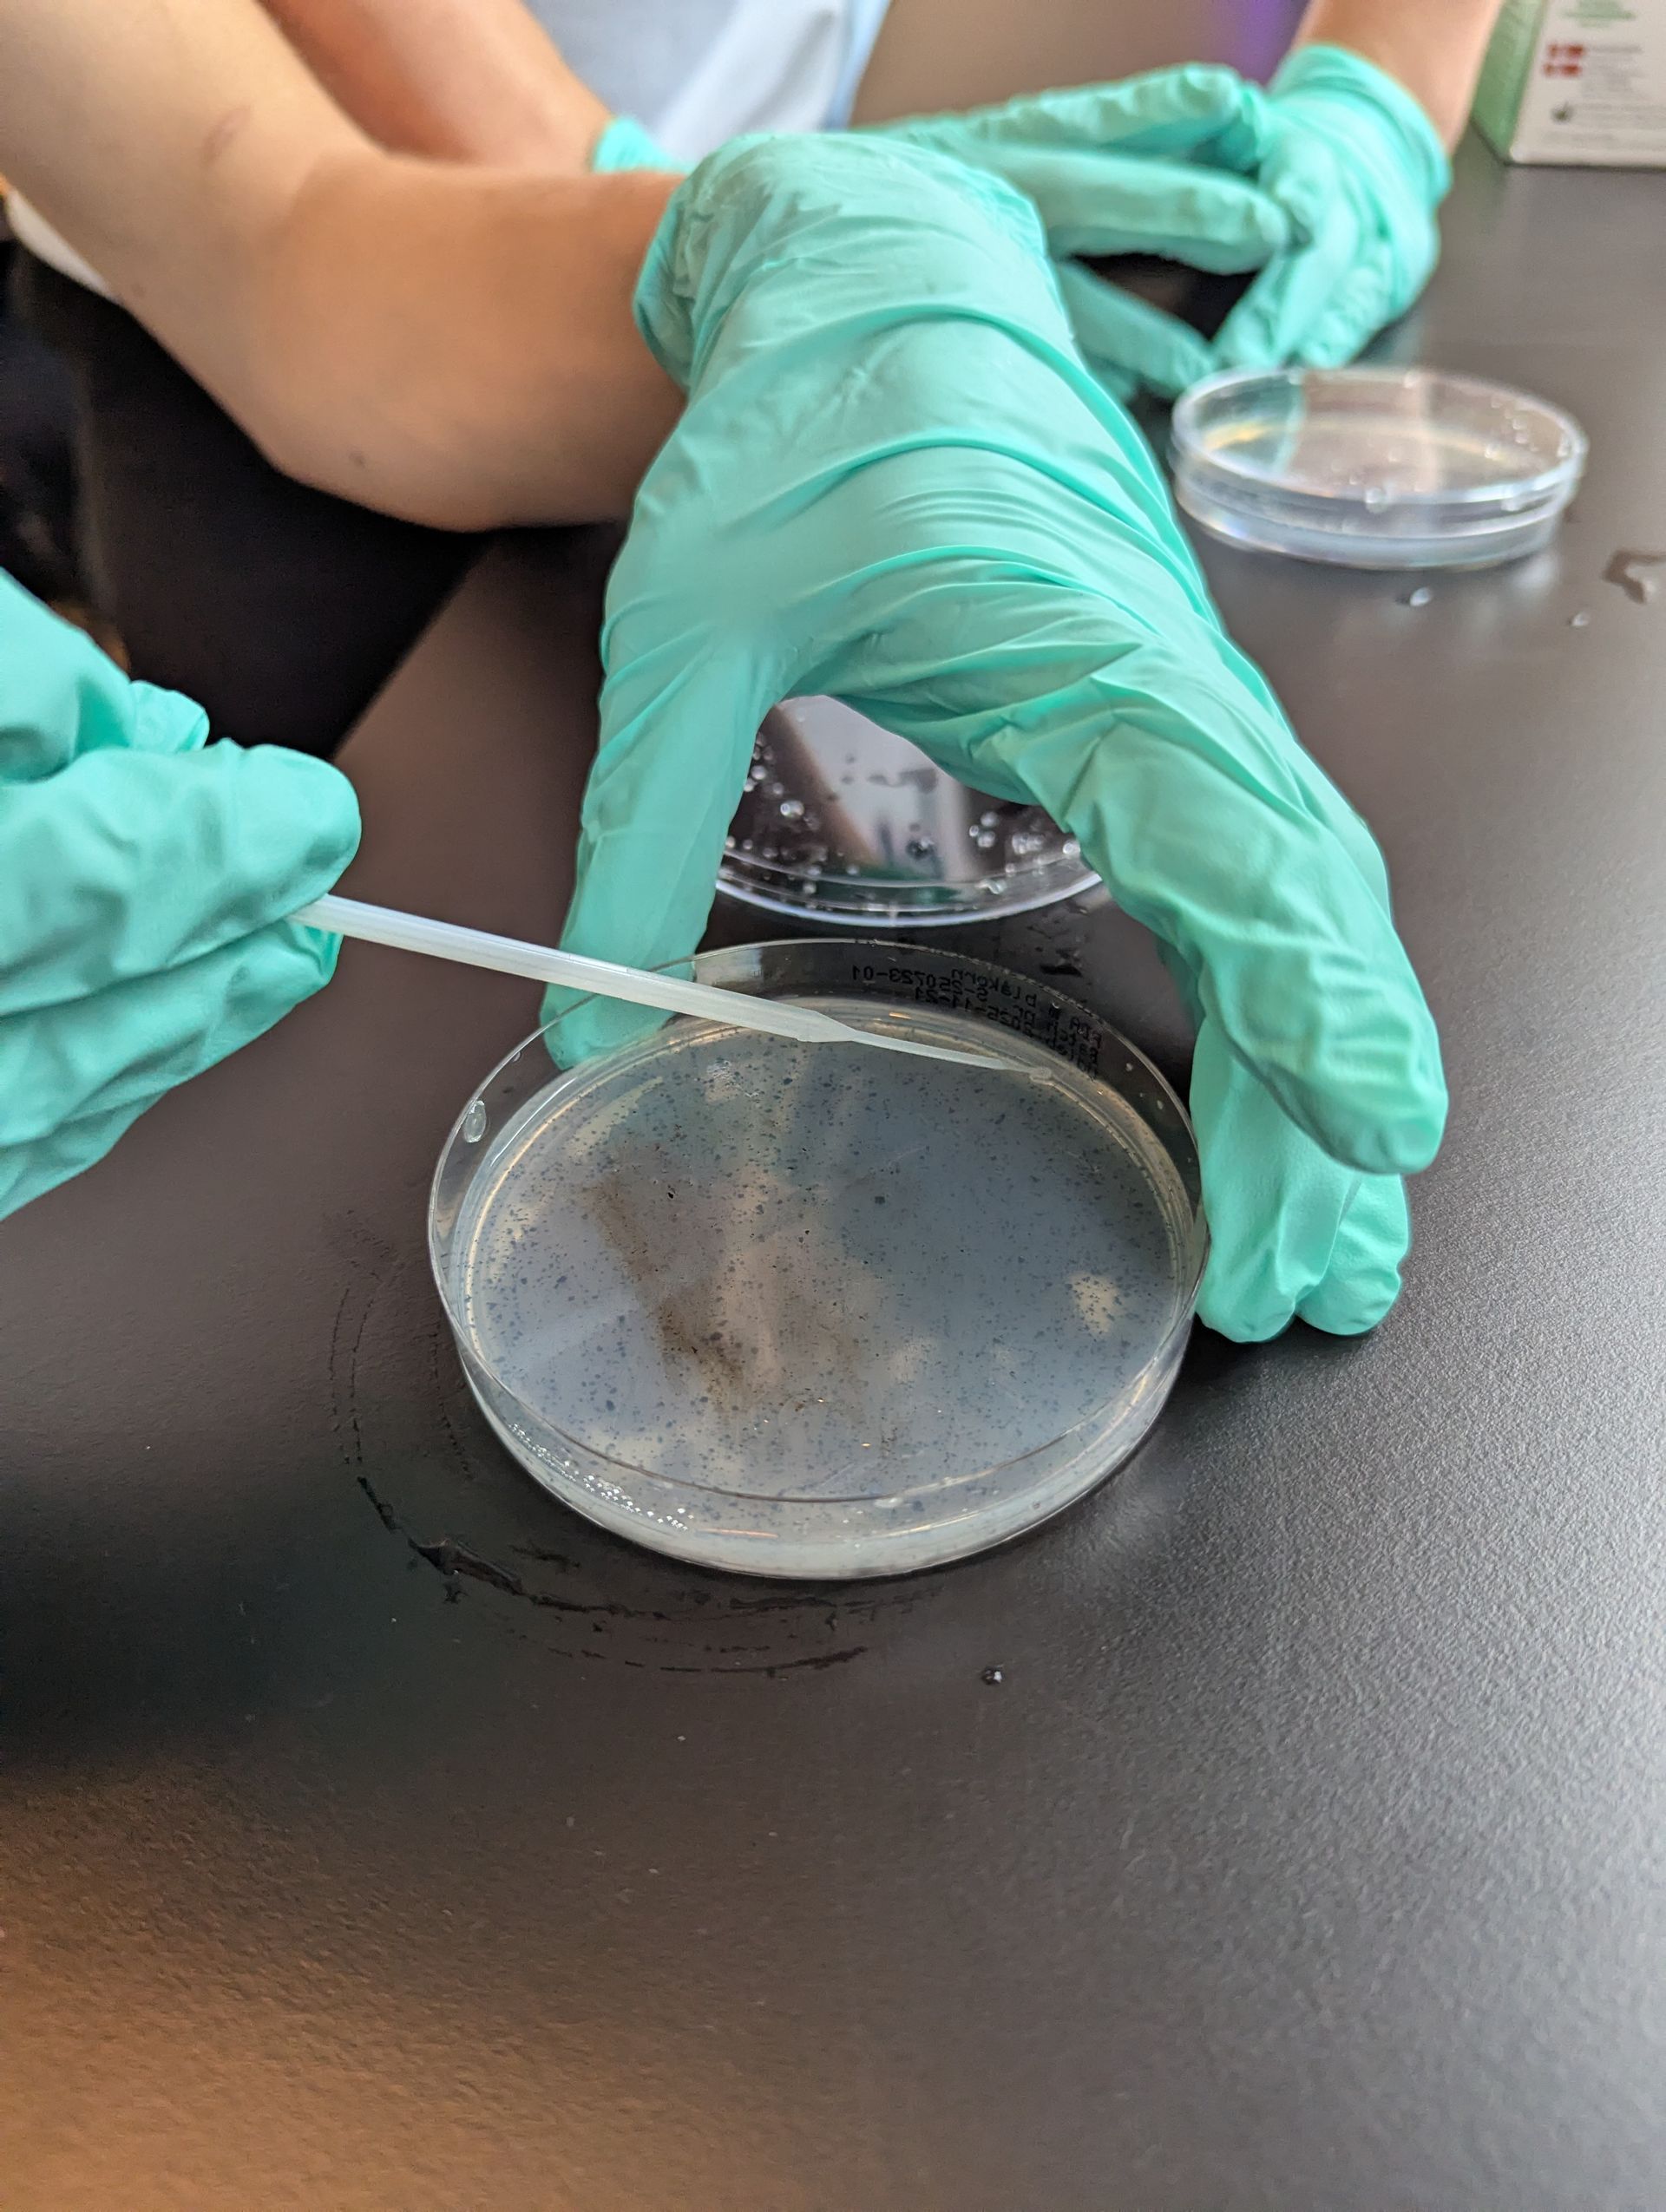

Emneuge 2025
Roskilde Private Skole
Dronning Sofies Vej 42, 4000 Roskilde, Denmark
Telefon: +45 4635 8612
Mail: rps@rps.dk
Roskilde Private Skole blev grundlagt i 1948 og blev i august 1968 overtaget af Syvendedags Adventistkirken. I 1972 blev skolen en selvejende institution. I Danmark findes 3 søsterskoler og en efterskole. Vi lægger vægt på det kristne livssyn, som danner grundlag for undervisningen, og for, hvordan elever og lærere omgås hinanden. Vi ønsker at skabe et trygt miljø for børnene og har fokus på, at børnene lærer at respektere hinandens forskelligheder.
Privatlivspolitik ElevIntra ForældreIntra PersonaleIntra Elevside Forældreside Lærerside MitUnilogin